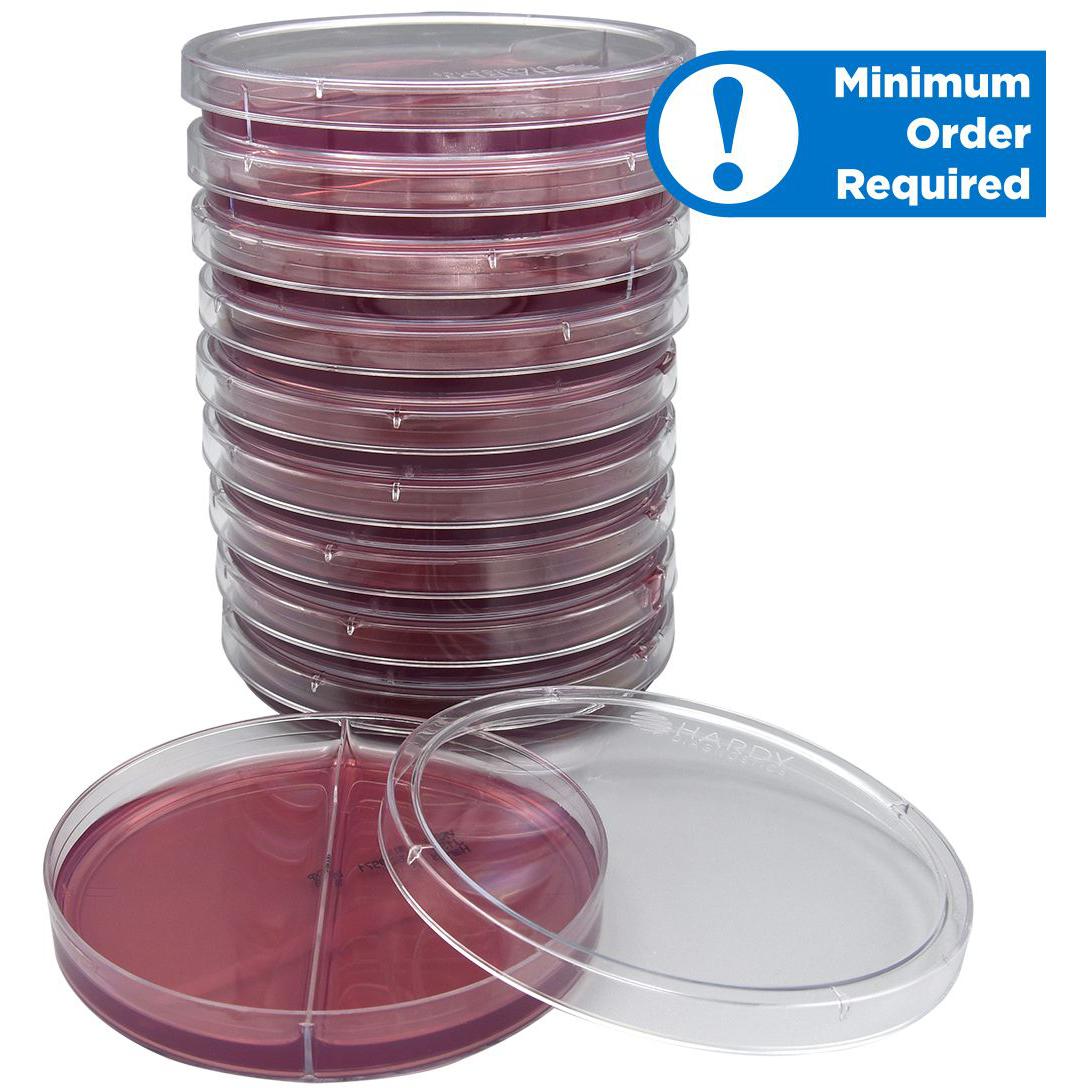

Violet Red Bile Agar (VRBA) with MUG (Methylumbelliferyl Glucuronide)/Violet Red Bile Agar (VRBA) with MUG, Biplate
$69
$62
SKU | Description | Quantity | Price | Add to Cart |
---|---|---|---|---|
J132 | Violet Red Bile Agar (VRBA) with MUG/Violet Red Bile Agar (VRBA) with MUG, 15x100 Biplate [MINIMUM ORDER: 6] |
10 Pack |
|
Description
Violet Red Bile Agar (VRBA) with MUG/Violet Red Bile Agar (VRBA) with MUG is for the detection of coliforms in food or dairy products.
Specifications
Manufacturer | Hardy Diagnostics |
---|---|
Pack Size | 10 per package |
Minimum Order | 6 packages of 10 |
Fill Volume | 10mL |
Dimensions | 15 x 100mm |